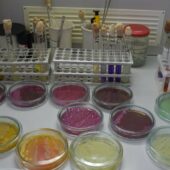
На Закарпатті у сирах з двох військових складів виявили бактерії кишкової палички

Біле золото Карпат – унікальний продукт.
Знак другого географічного зазначення отримає гуцульська коров’яча бринза, яку виготовляють в Івано-Франківській області. «Перший кабельний» піднявся на сотню метрів над рівнем моря, аби дістатися полонин, де готують автентичний сир та поспілкуватися із ватагами.
У їхньому ремеслі закладені слова: «Щастя не за горами, щастя – у горах».

Файний репоптаж